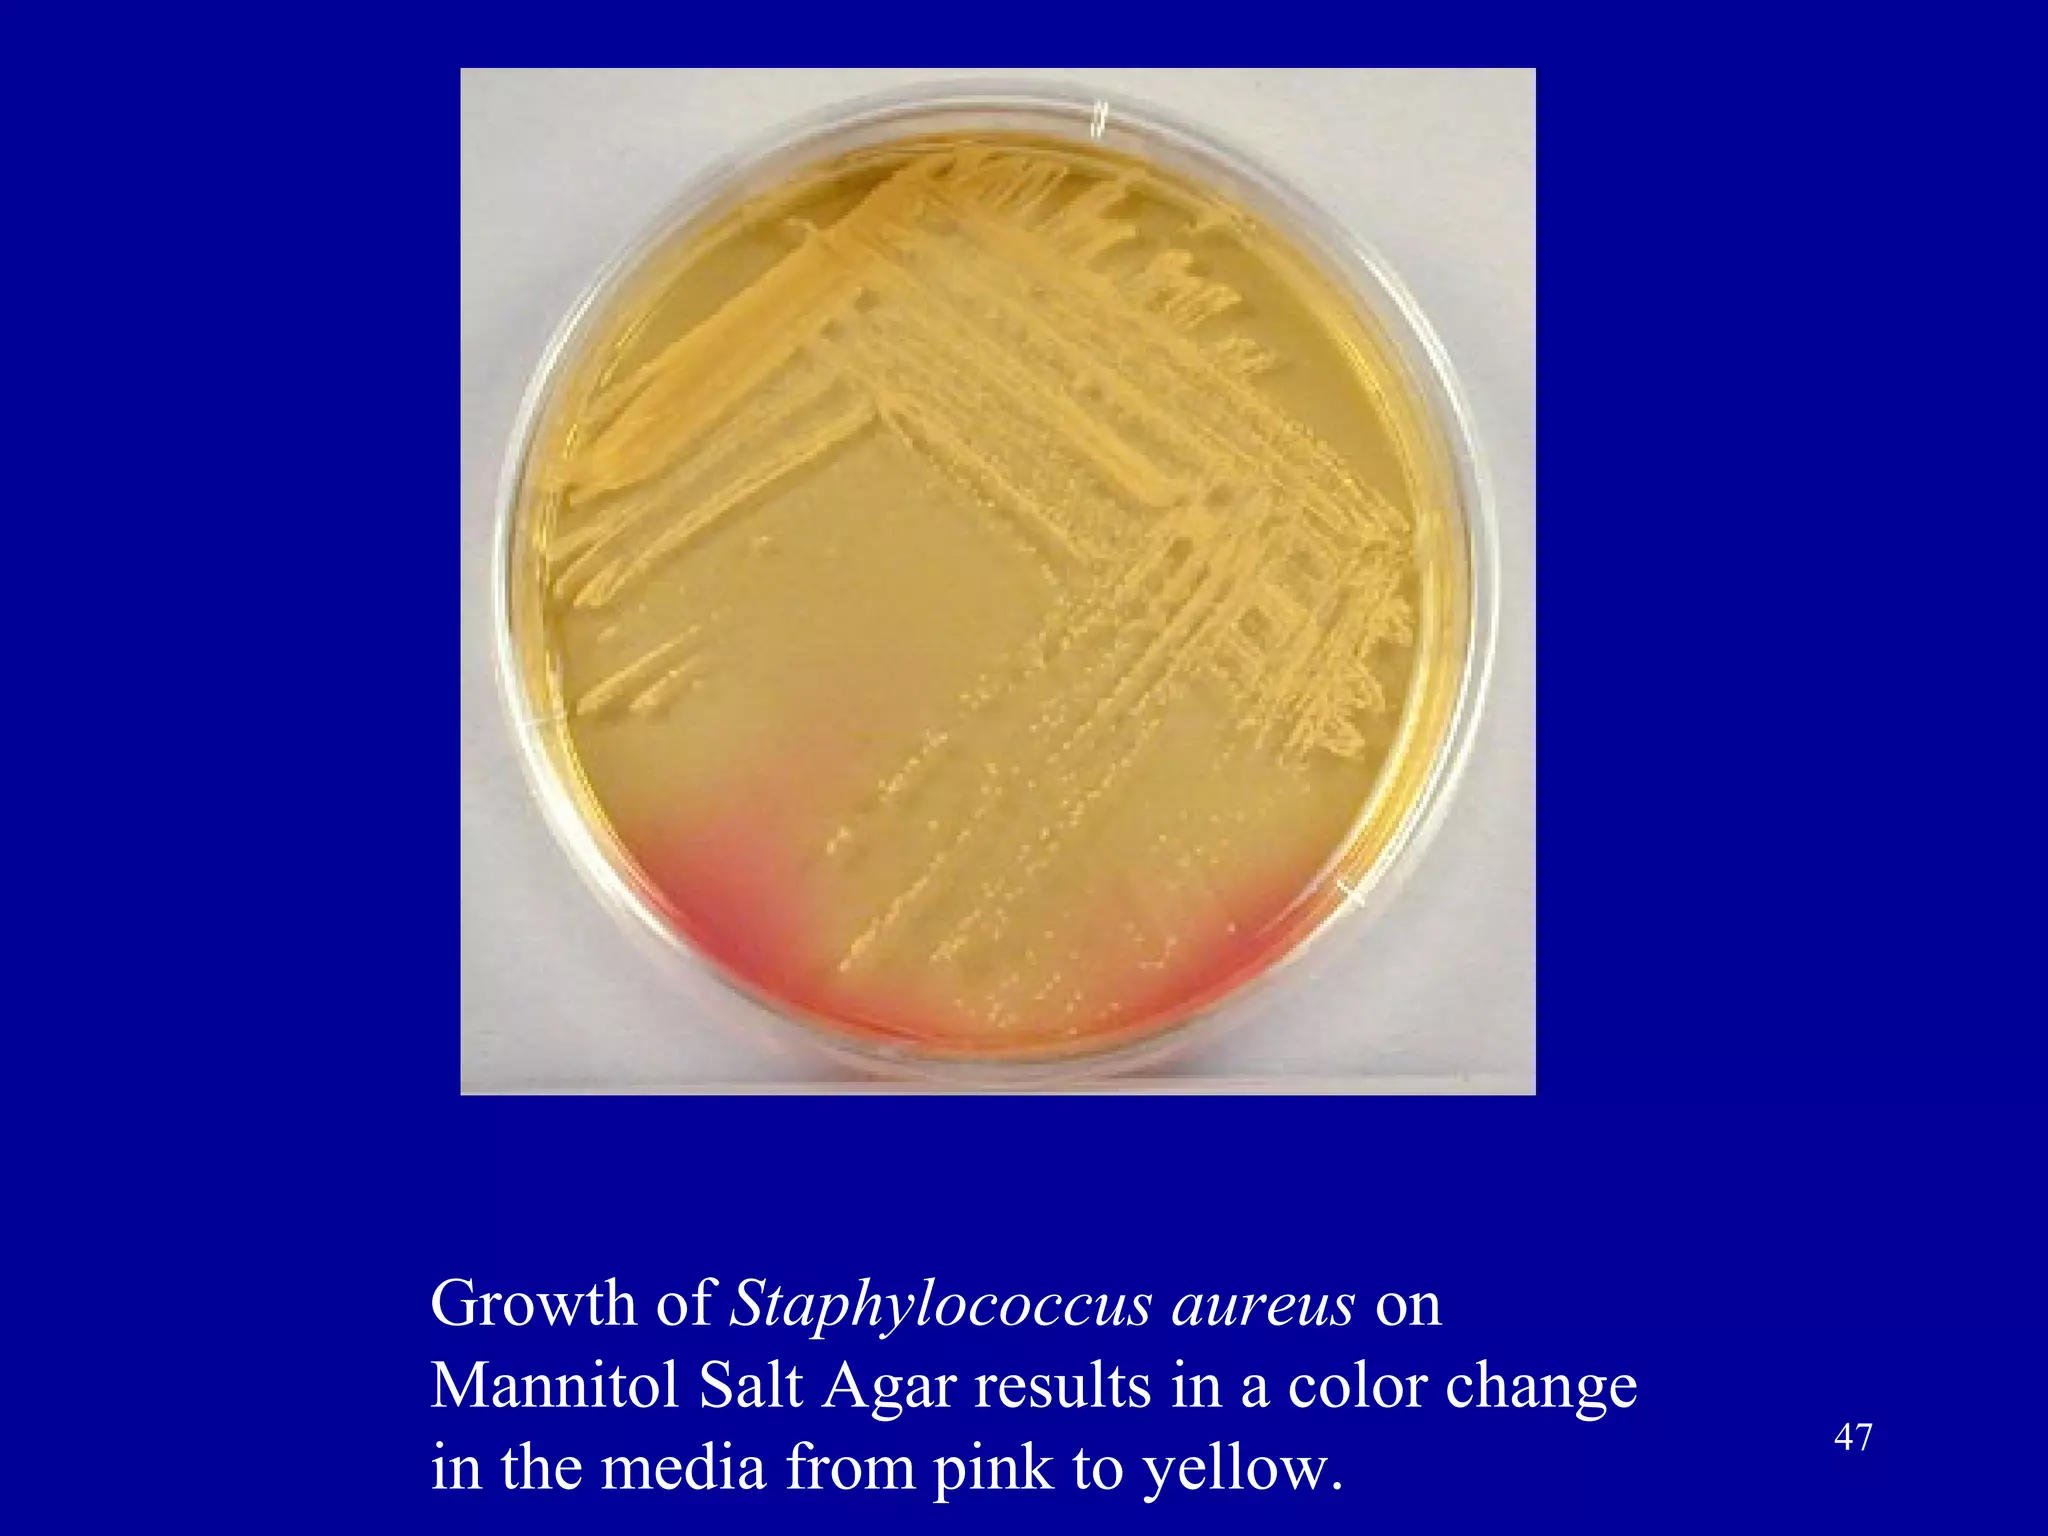
Growth of Staphylococcus aureus on
Mannitol Salt Agar results in a color change
                                               47
in the media from pink to yellow.
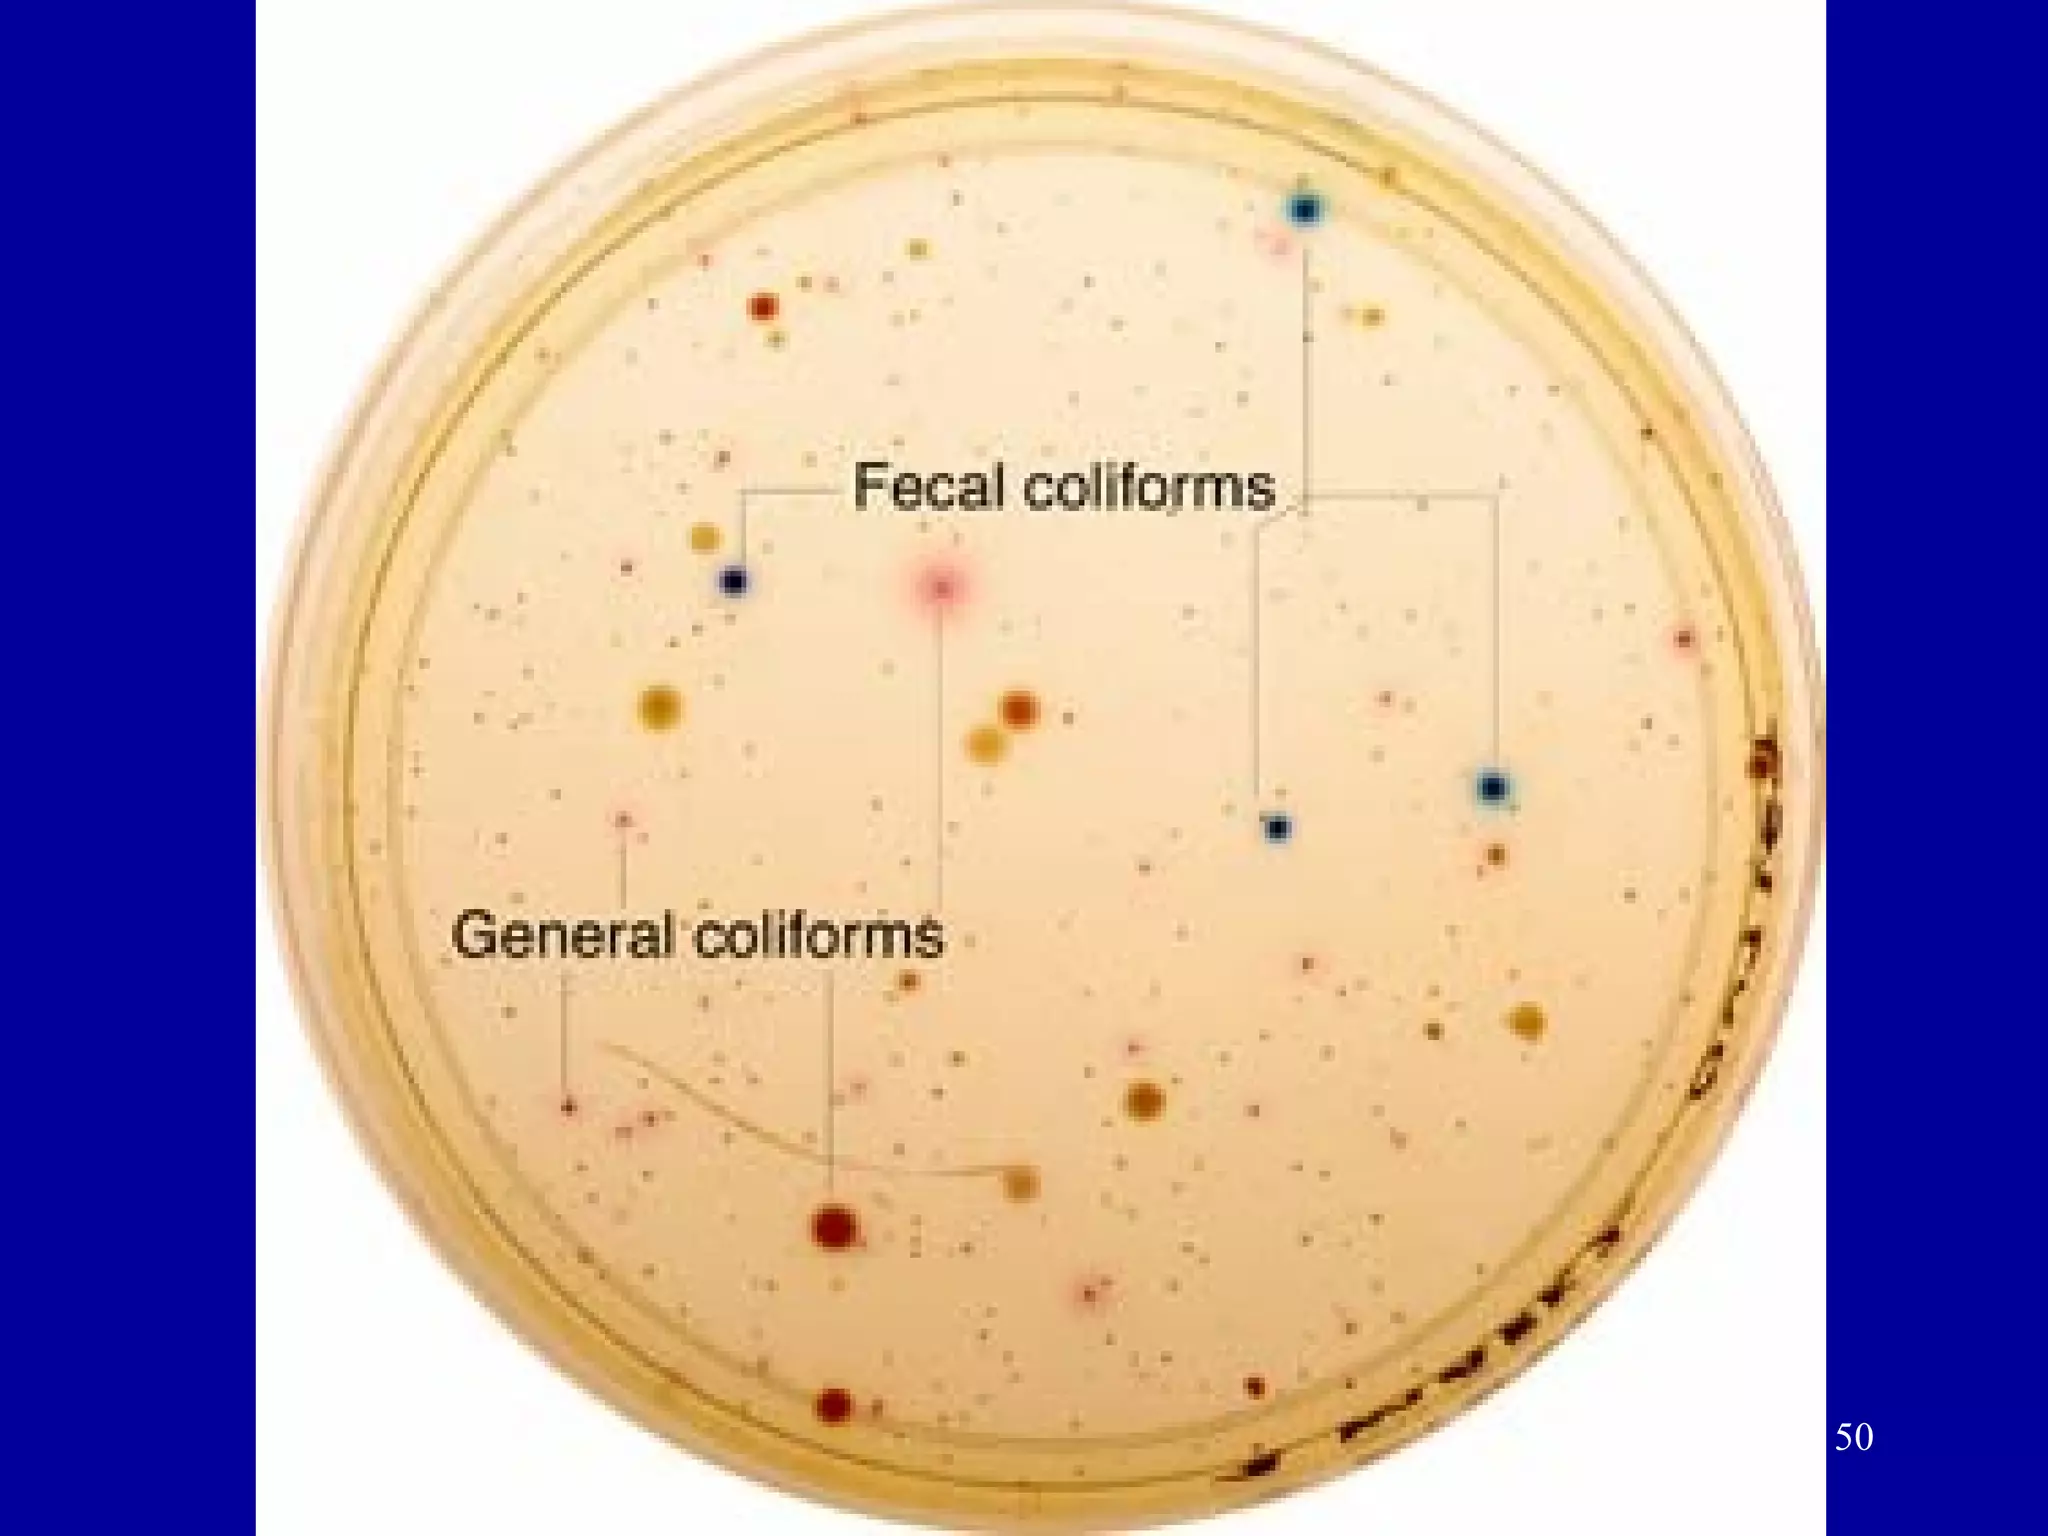
50
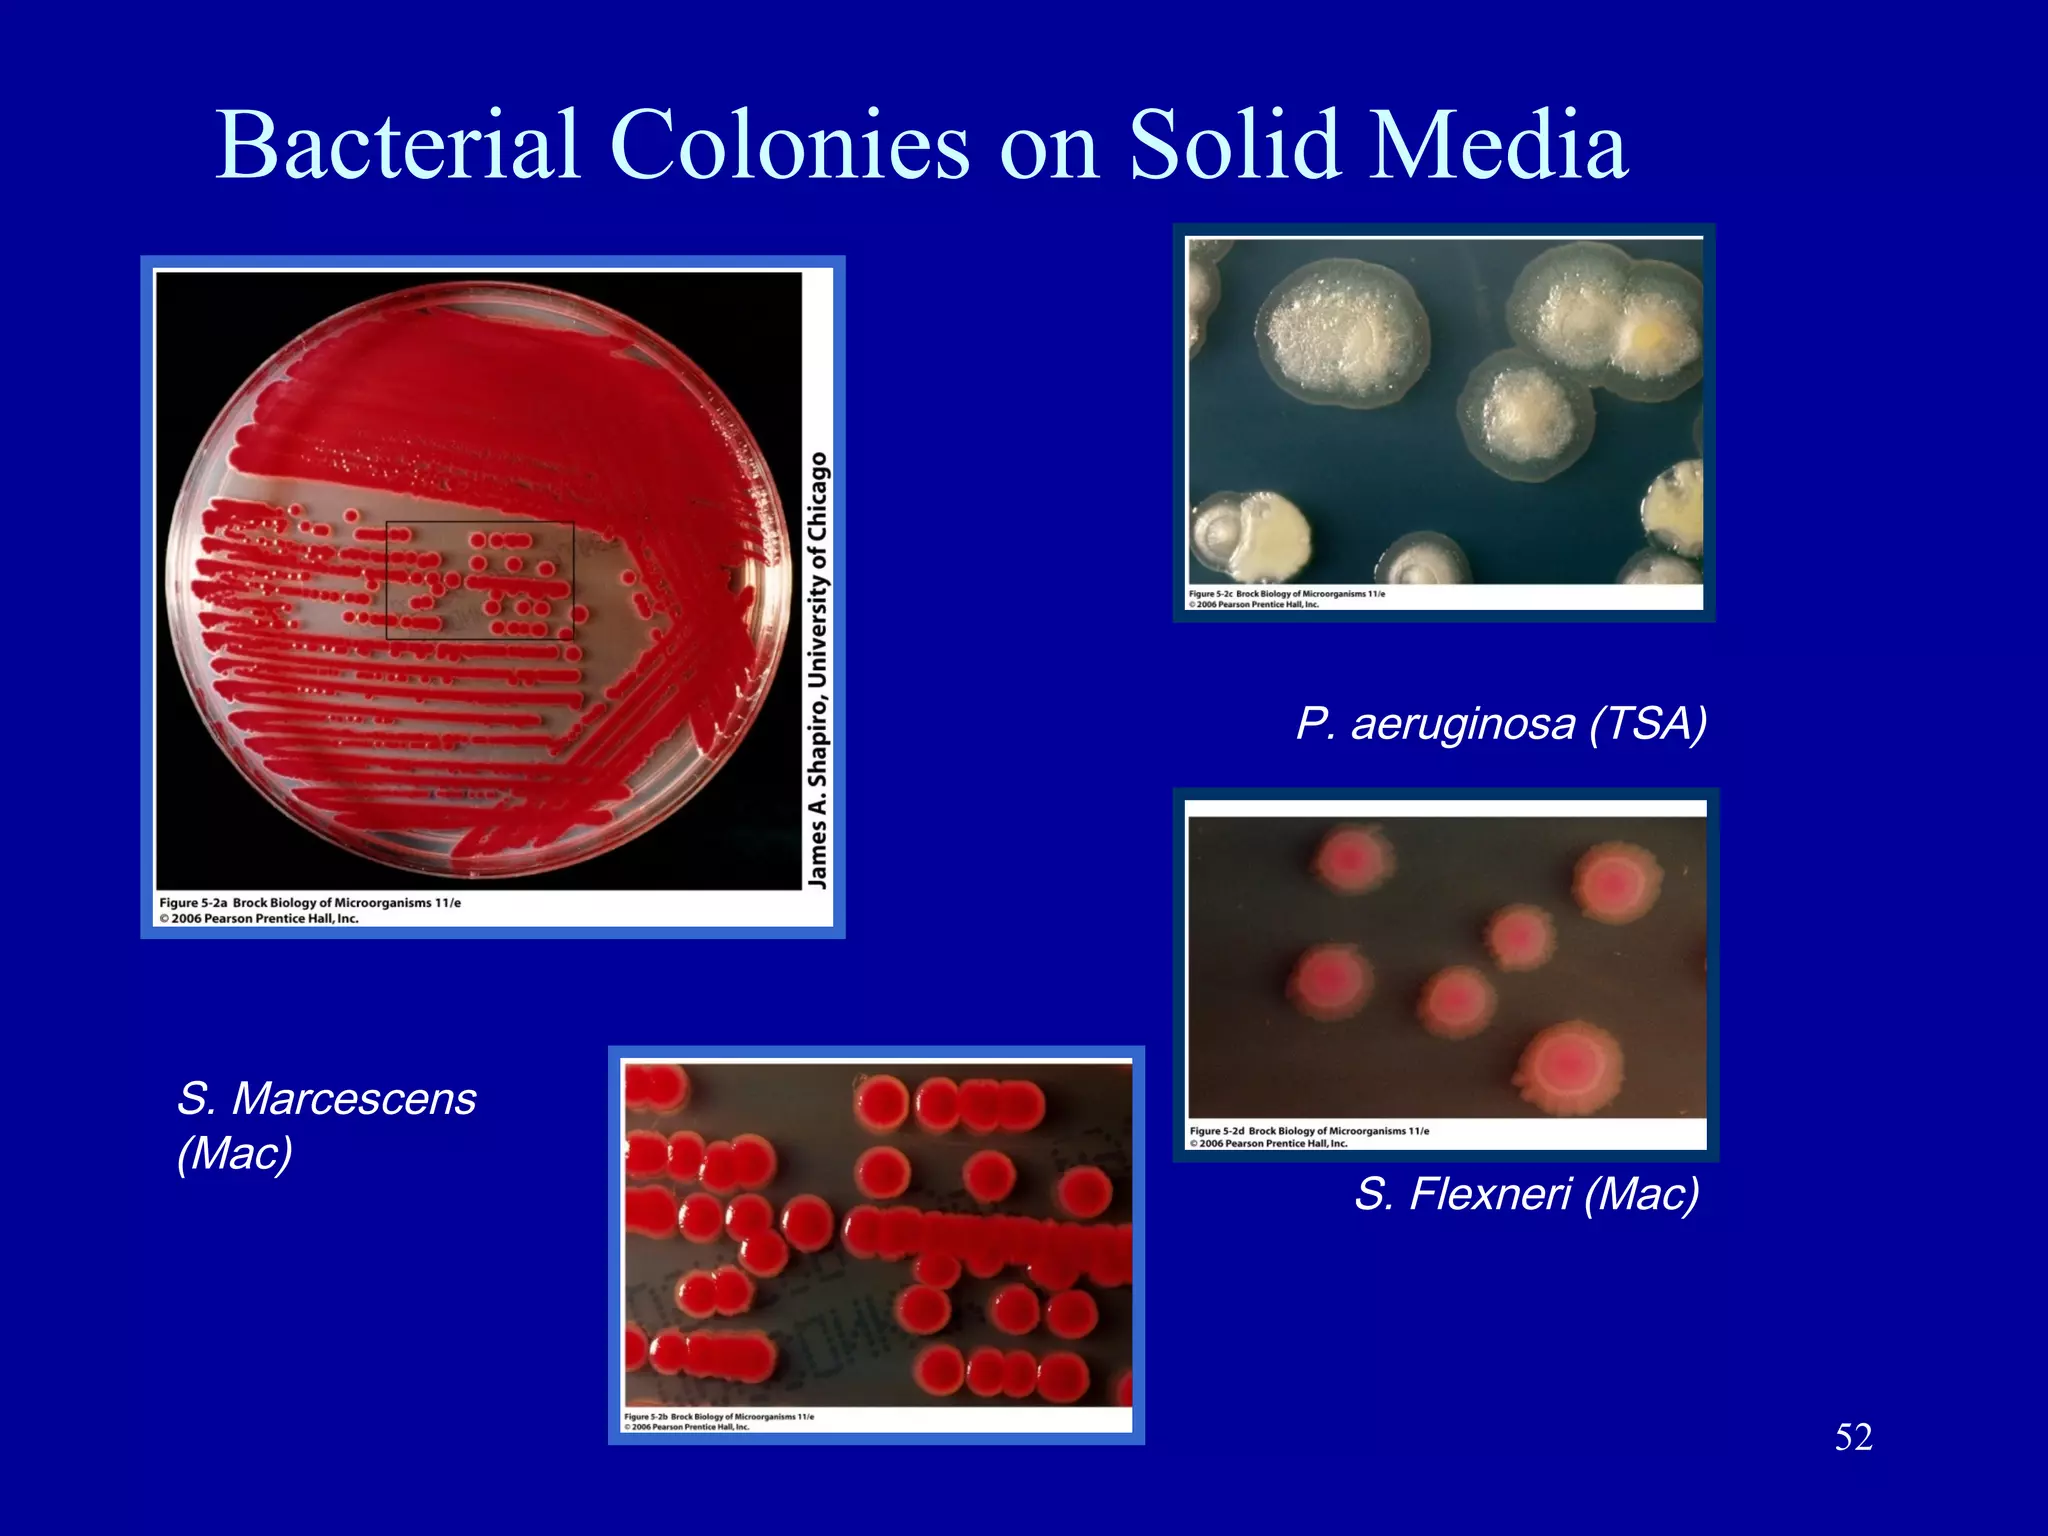
Bacterial Colonies on Solid Media




                          P. aeruginosa (TSA)




S. Marcescens
(Mac)
                            S. Flexneri (Mac)




                                                52
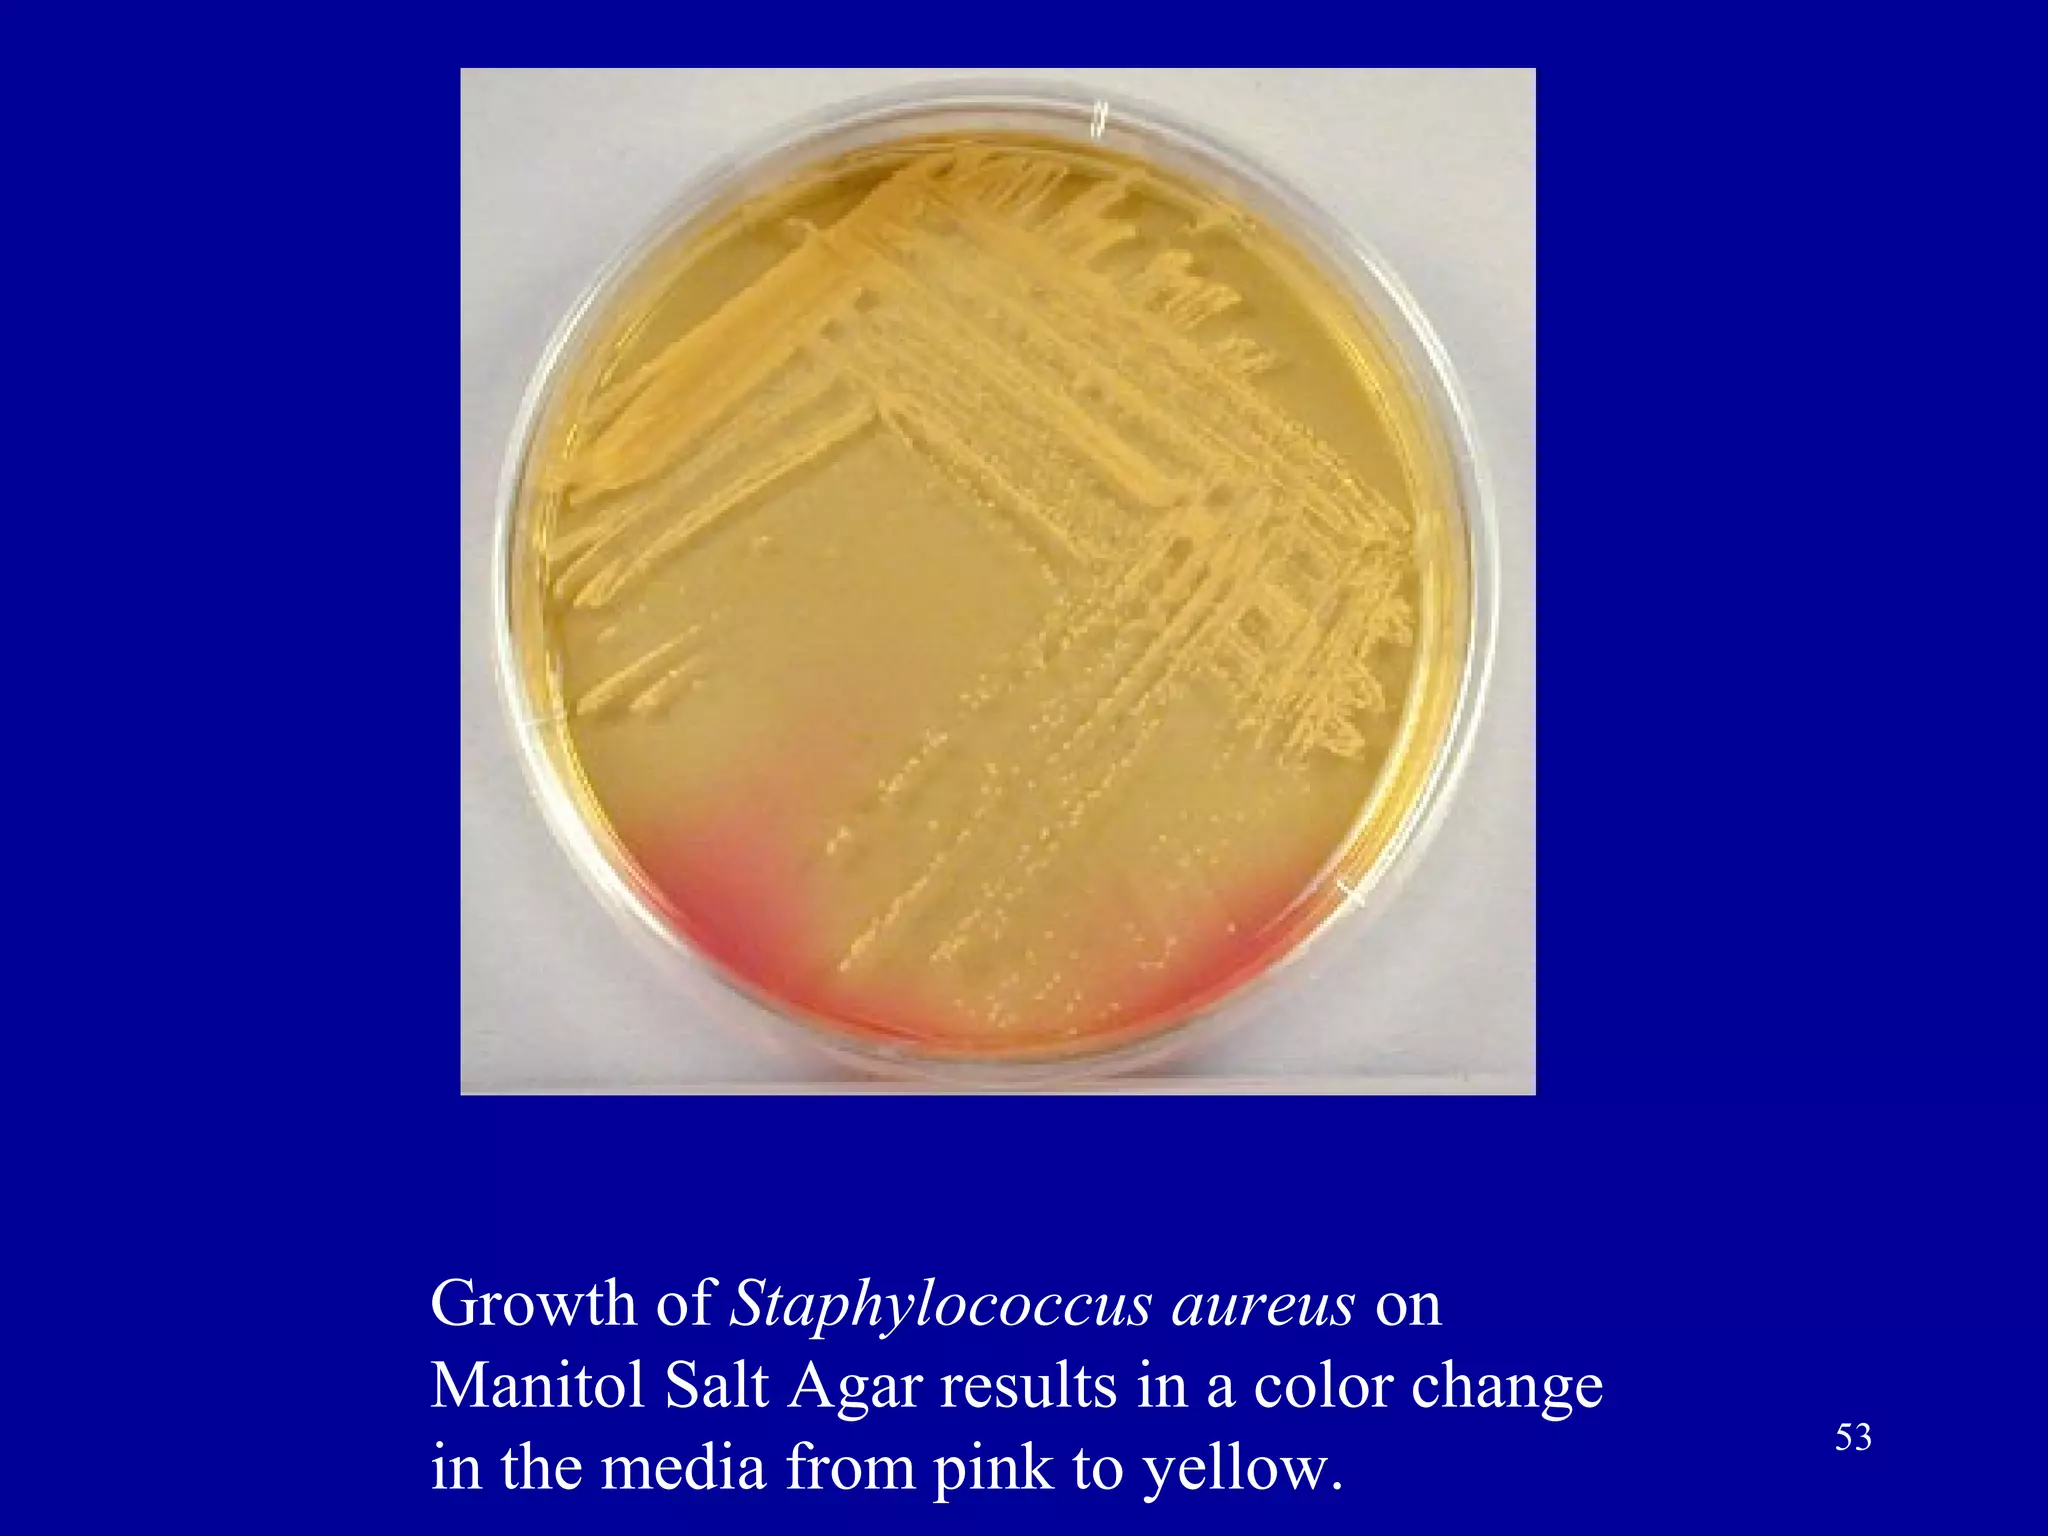
Growth of Staphylococcus aureus on
Manitol Salt Agar results in a color change
                                              53
in the media from pink to yellow.
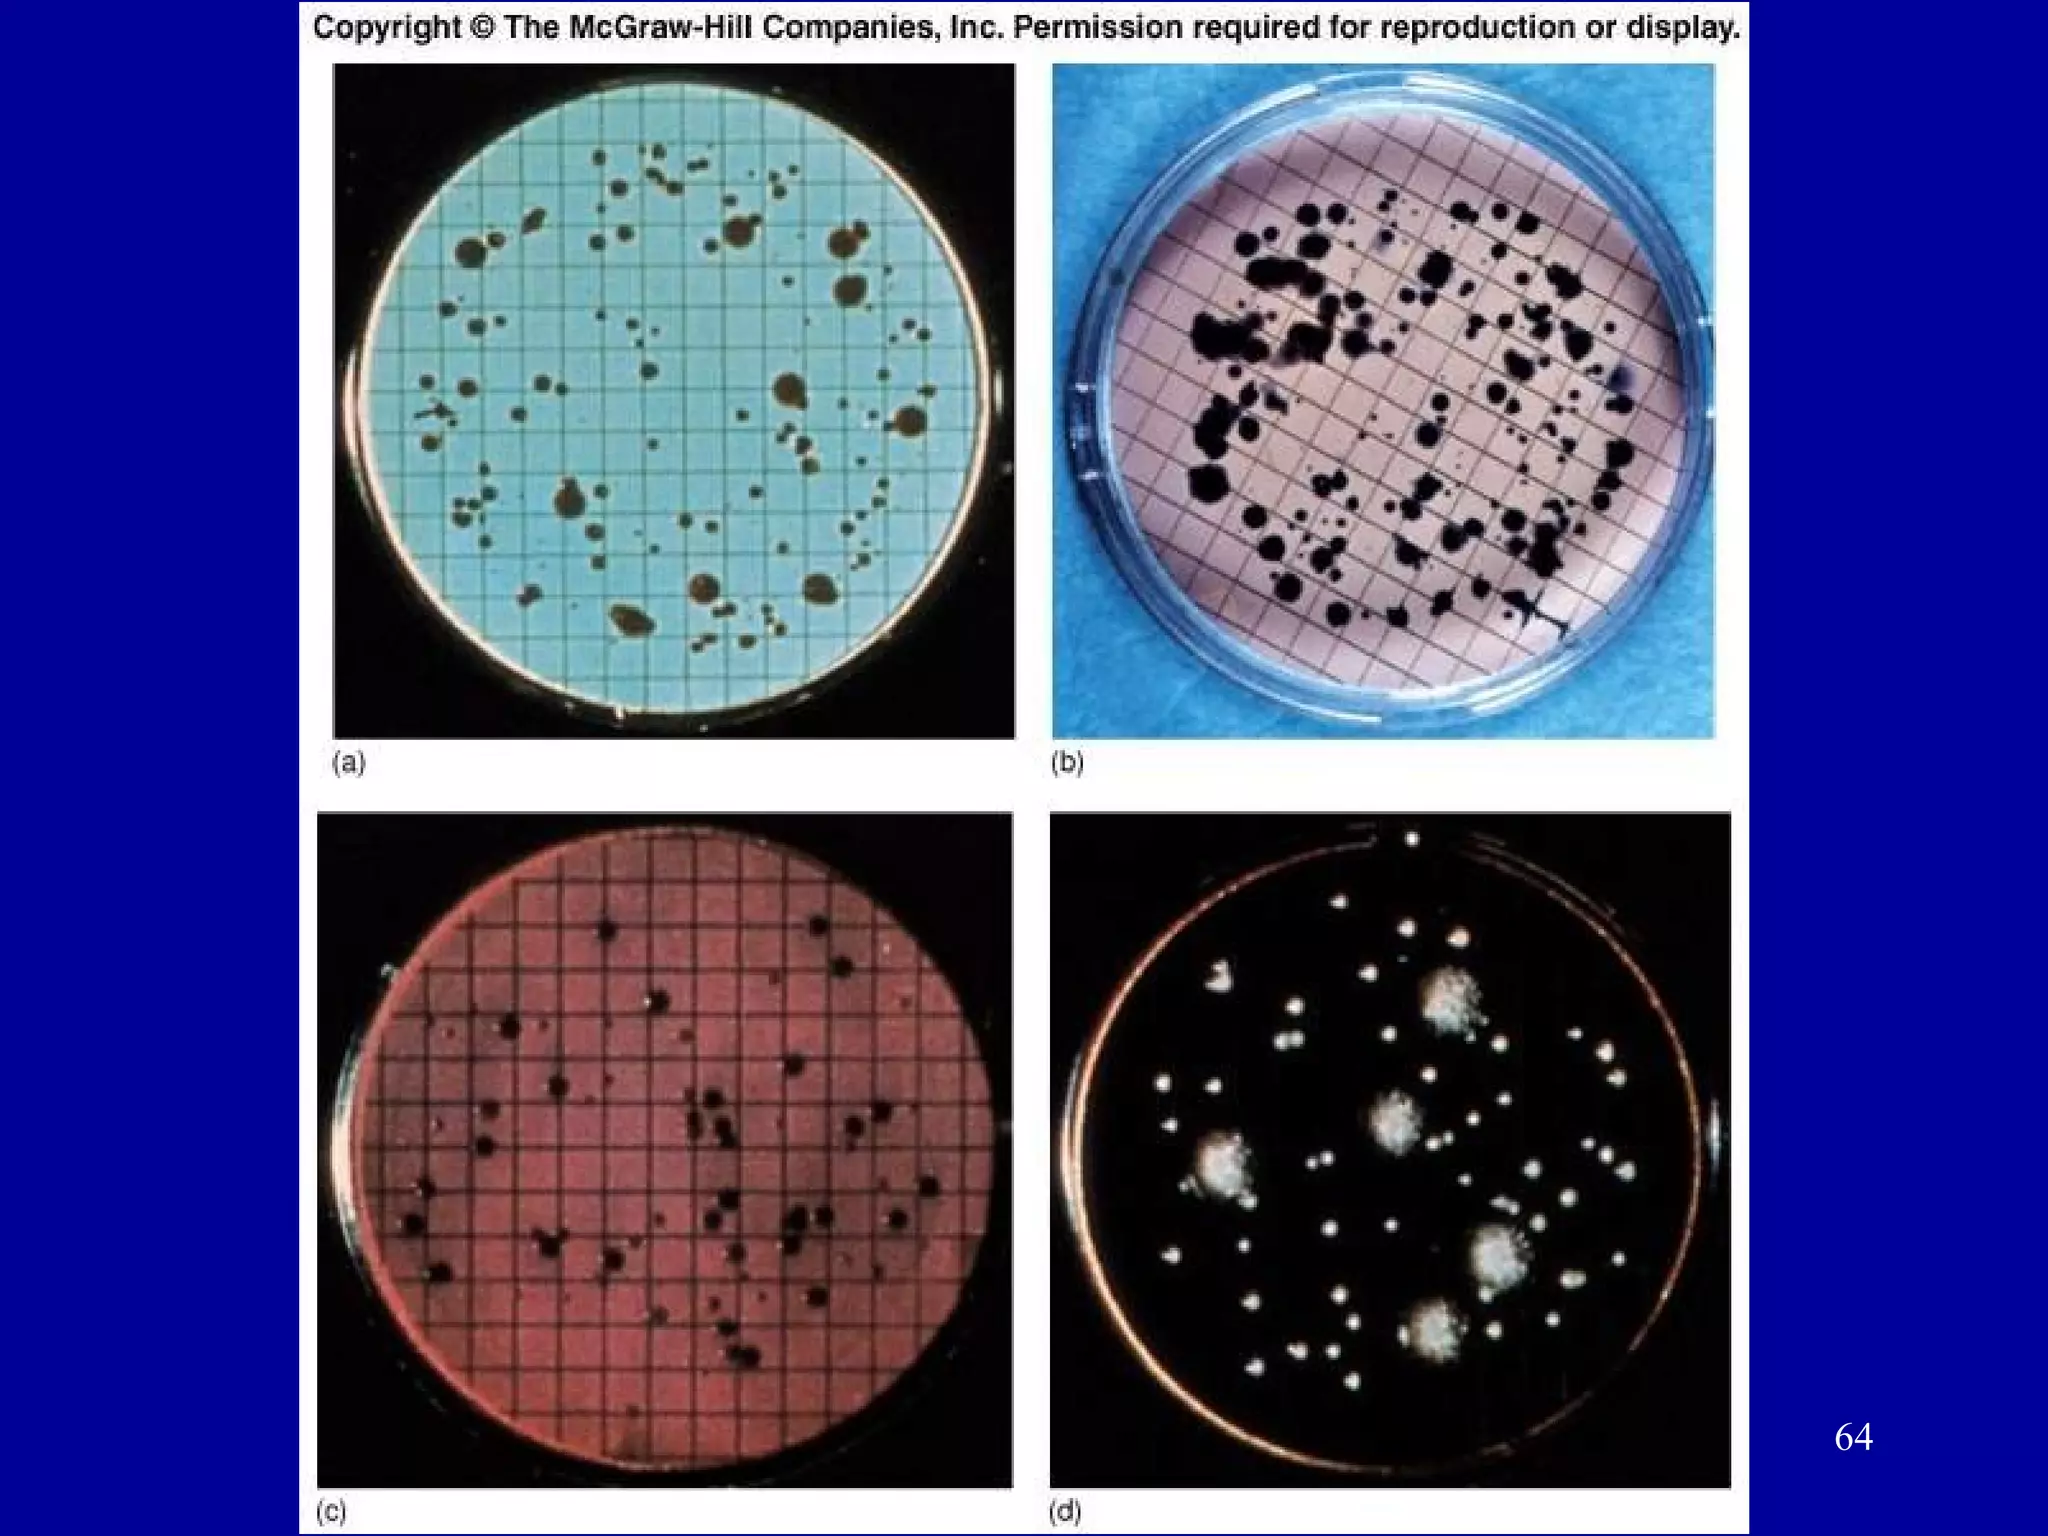
64

This document discusses microbial nutrition and growth. It covers the classification of microorganisms based on their temperature, pH, osmotic pressure, and oxygen requirements. Key points include:
- Microbes are classified as mesophiles, psychrophiles, thermophiles, or hyperthermophiles based on their optimal temperature ranges.
- Most microbes grow best between pH 6-8 but some are acidophiles or alkaliphiles that prefer more extreme pH levels.
- Halophiles and barophiles thrive in high salt or pressure environments while others are merely tolerant.
- Microbes obtain carbon, energy, nitrogen, phosphorus and other nutrients from their environment and are classified based on these









![pH and Microbial Growth
pH – measure of [H+]
each organism has a pH range and a pH optimum
acidophiles – optimum in pH range 1-4
alkalophiles – optimum in pH range 8.5-11
lactic acid bacteria – 4-7
Thiobacillus thiooxidans – 2.2-2.8
fungi – 4-6
internal pH regulated by BUFFERS and near neutral
adjusted with ion pumps
Human blood and tissues has pH 7.2+0.2
10](https://image.slidesharecdn.com/lecture3-bacterialnutritionandgrowth-120813103254-phpapp02/75/Lecture-3-bacterial-nutrition-and-growth-10-2048.jpg)



































![Selective Media
• Contains one or more agents that inhibit the
growth of a certain microbe and thereby
encourages, or selects, a specific microbe.
• Example: Mannitol Salt Agar [MSA]
encourages the growth of S. aureus. MSA
contain 7.5% NaCl which inhibit the growth
of other Gram +ve bacteria
46](https://image.slidesharecdn.com/lecture3-bacterialnutritionandgrowth-120813103254-phpapp02/75/Lecture-3-bacterial-nutrition-and-growth-46-2048.jpg)